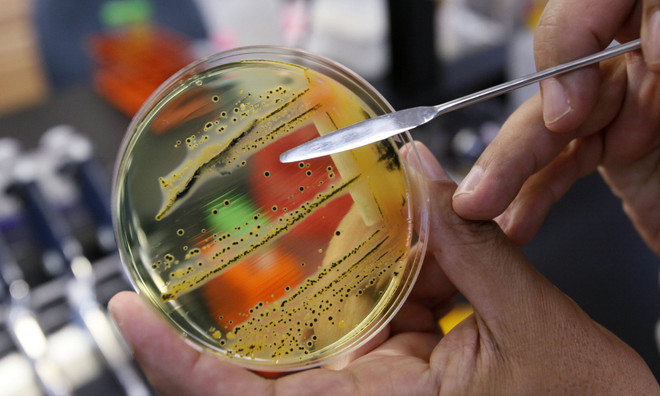
WHO công bố danh sách 12 siêu vi khuẩn đáng lo ngại nhất ảnh 1

Ảnh minh họa. (Nguồn: AP)
Ảnh minh họa. (Nguồn: AP)
Theo phóng viên TTXVN tại châu Âu, ngày 27/2, Tổ chức Y tế Thế giới (WHO) đã công bố một danh sách 12 nhóm vi khuẩn mà thế giới phải cấp thiết phát triển các loại thuốc kháng sinh mới để đối phó, vì nguy cơ những vi khuẩn này chống lại các phương pháp điều trị hiện nay là rất đáng lo ngại. Nhóm vi khuẩn nguy hiểm nhất bao gồm các vi khuẩn đa kháng.
Chúng là mối đe dọa đặc biệt nghiêm trọng tại các bệnh viện, nhà điều dưỡng chăm sóc người già và đối với các bệnh nhân sử dụng máy hô hấp hoặc ống thông máu. Những vi khuẩn như Acinetobacter, Pseudomonas và một số vi khuẩn khác có thể gây nhiễm khuẩn, nhiễm trùng nghiêm trọng. Hai nhóm vi khuẩn khác, với những ưu tiên xử lý ở cấp độ cao và trung bình, bao gồm những chủng vi khuẩn ngày càng có khả năng kháng thuốc cao, dẫn đến các bệnh thường gặp.
Để đánh giá nguy cơ của các vi khuẩn này trong danh sách nói trên, các nhà khoa học của WHO dựa trên nhiều tiêu chuẩn như mức độ gây tử vong của các nhiễm trùng, thời gian lưu trú trong bệnh viện để chữa trị, mức độ kháng kháng sinh hoặc khả năng lây lan của vi khuẩn.
Theo Phó tổng giám đốc WHO Marie-Paule Kieny, danh sách những nhóm vi khuẩn này cần phải được chủ ý để giúp tăng cường các nghiên cứu tìm ra các loại thuốc chống lại các tác nhân gây bệnh, nhằm đáp ứng "nhu cầu cấp bách của y tế cộng đồng."
WHO cũng kêu gọi tăng cường phòng ngừa, kiểm soát các nhiễm khuẩn và sử dụng kháng sinh ở người và các loài động vật khác. Ngoài ra, các khả năng phòng ngừa, số lượng các khả năng lựa chọn điều trị còn tác dụng và sự sẵn có của thuốc kháng sinh mới cũng là các yếu tố được các nhà khoa học tính đến./.





































